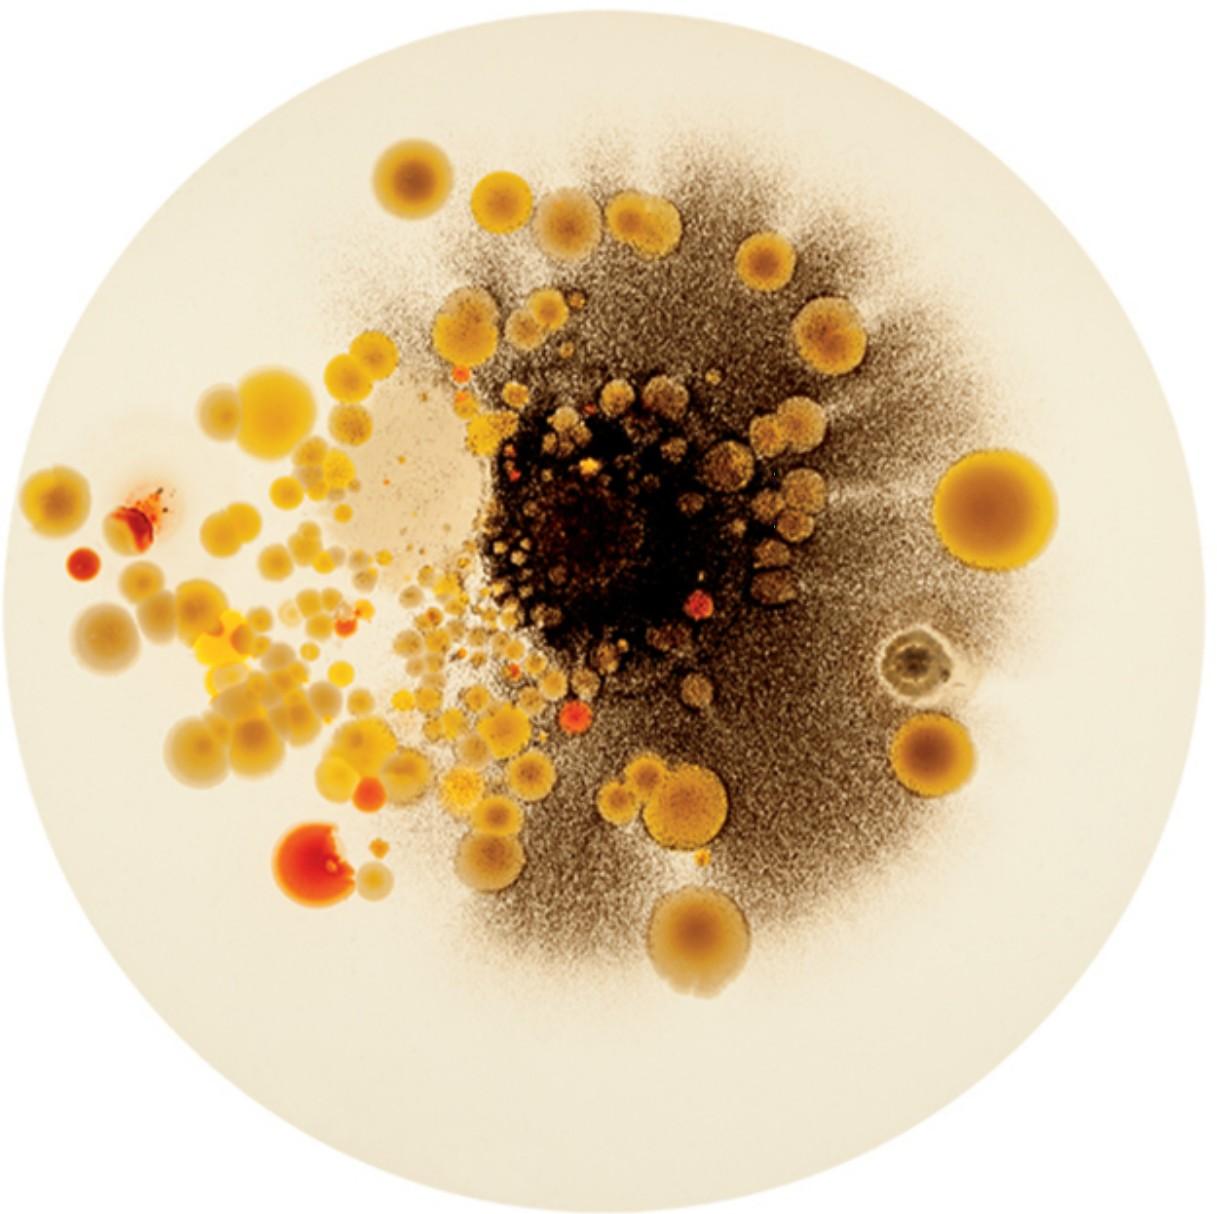
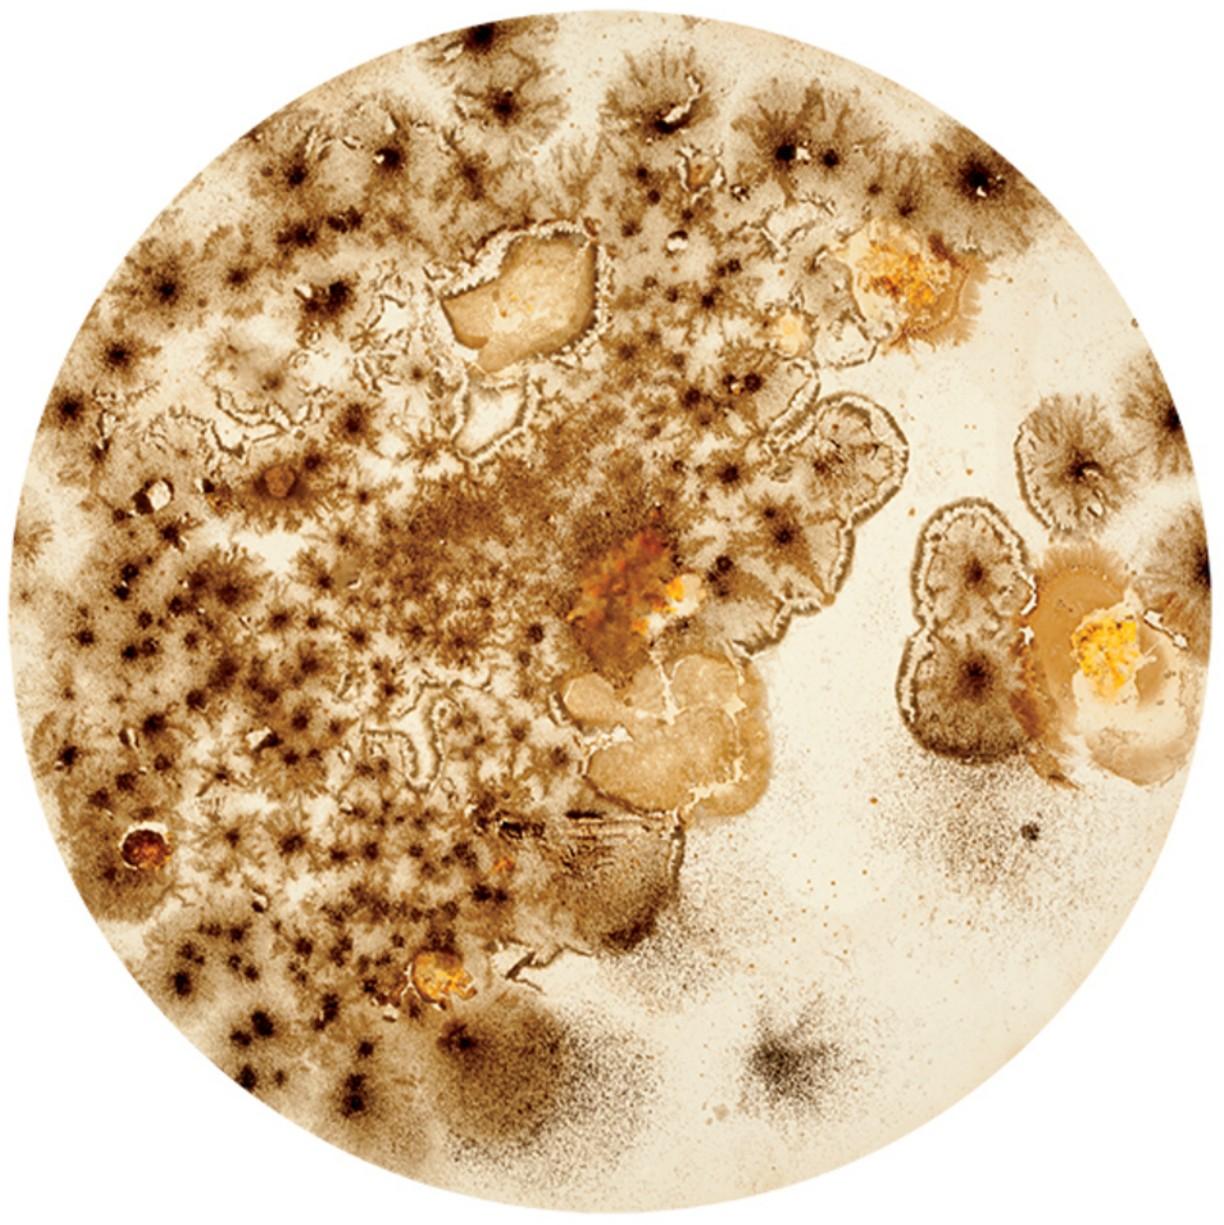

მეტაფაზა – უხილავი დინებები, ცოდნის სტრუქტურები და ყოფის ანატომია
ავტორი: მარიამ შერგელაშვილი
უხილავი დინებები და ცოდნის ორგანიზებული სტრუქტურები ერთად ქმნის ყოფის ანატომიას; ანატომიას, რომელშიც სიცოცხლე არა სტატიკური, არა სწორხაზოვანი, არამედ მუდამ მოძრაობაში გამოვლენილი ფენომენია.
სიცოცხლის მიკროდონეზე, უჯრედულ აგებულებაში არსებული ფაზებიც პროცესია, რაც ერთიან ორგანიზმად ყალიბდება. მეტაფაზა ბიოლოგიაში უჯრედული გაყოფის შუალედური ფაზაა. უჯრედის ციკლში მეტაფაზას ეტაპზე მთელი გენეტიკური მასალა კონდენსირდება ქრომოსომებში. შემდეგ ეს ქრომოსომები ხილული ხდება მიკროსკოპის ქვეშ.
მეტაფაზაში შემავალი უჯრედები გამოიყენება სამედიცინო კვლევისას. მეტა – შორის, ფაზა – გამჟღავნება – სიტყვის ამგვარი გაშიფვრით ბიოლოგიური ტერმინის მიღმა ძლიერი ვიზუალური შინაარსის გამომხატველ განმარტებას ვიღებთ. მეტაფაზა ჩემთვის შეკითხვაა, დაყოვნება იმაზე დასაფიქრებლად, თუ რა მჟღავნდება ჩვენთვის სამყაროში, როდესაც აღქმა, ხედვის პერსპექტივა არამხოლოდ ეგოცენტრულ და თავის თავზე ორიენტირებულ მიდგომებს აერთიანებს? როგორ შემოდის აზროვნებაში მეტაფორული შრეები და რა მიმართებას აყალიბებს ეს იმ ეკოსისტემაზე, რომელშიც განსხვავებული ხედვისა და ინტერესების მქონე ადამიანები განსხვავებულ ცოცხალ ორგანიზმებთან ერთად თანავარსებობთ?
ამ განსხვავების ალტერნატივის ძიებამ სხვადასხვა ცოცხალი ორგანიზმის კვლევაზე/დაკვირვებაზე ორიენტირებული სახელოვნებო ხედვები განავითარა. ამგვარი ეკოხედვით ხდება კრიტიკული გადააზრება ადამიანის, რომელიც ისტორიულად დომინანტურ პატრიარქალურ წყობაში დღემდე მყარად მხოლოდ საკუთარი კომფორტის ზონას ქმნის. ეტაფაზა კითხვებისა და ძიების პროცესს თანამედროვე სახელოვნებო პრაქტიკების მეშვეობით წარმოადგენს. სტატიაში მიმოვიხილავ ეკოხედვას, როგორც სახელოვნებო ალტერნატივას – აზროვნების მოდელს.
ხელოვნება ისტორიულად სამყაროს მეტაფორულ წვდომას გამოხატავდა. თუმცა დღევანდელობა გვანახვებს, რომ ისტორიული ანთროპოცენტრული ხედვა საუკუნეების განმავლობაში ადამიანის დომინაციური ხედვით თვითამოწურვად კრიზისამდე განვითარდა. მაშინ როგორი უნდა იყოს ალტერნატიული პერსპექტივა? იქნებ ადამიანიც, თავისივე უჯრედის მსგავსად, უნდა შეჩერდეს, დაყოვნდეს მეტაფაზაში და მიკროსკოპულად დააკვირდეს თავის ქმედებას, რომელიც სინამდვილეში ურთიერთქმედების უწყვეტი ჯაჭვია?
აბრეშუმის მუზეუმში მუშაობამ განსაზღვრა ჩემი მიმართების ჩამოყალიბება თანამედროვე ხელოვნებასთან კავშირით – მუზეუმის დღევანდელი ხედვა ცოდნის გაანალიზებას ეფუძნება. ახალი ცოდნის ფორმა (ცოდნის ანალიზი) ნიშნავს მეცნიერული მიდგომების, შემოქმედებითი, გრძნობად-ემოციური ინტერპრეტაციების, ინტუიციისა და ისტორიული ფაქტების ერთ სისტემაში თავმოყრას.
როდესაც პირველად აბრეშუმხვევიას სასიცოცხლო ციკლზე დაკვირვება დავიწყე, მოსაზღვრული ტერიტორიები მეცნიერულ ცოდნასა და ამ ცოდნის მეტაფორულ აღქმას შორის თანდათან წაიშალა. აბრეშუმხვევიას გარდაქმნადი, ციკლური ცხოვრება, რომელშიც ის საკვებს (თუთის ფოთოლს) საკუთარ სხეულში აბრეშუმის ძვირფას მასალად აქცევს, ეტაპობრივად გახდა ჩემთვის შემეცნების, პროცესზე ორიენტირებული ხედვის სიმბოლო.
დისციპლინების, დარგებისა და შემეცნებითი მოდელების დაკავშირება აბრეშუმის მუზეუმის თანამშრომლობით სტრატეგიას აყალიბებს. სწორედ ამ ხედვებისა და იდეების ურთიერთდაკავშირების ერთ-ერთი მაგალითია ავსტრალიელი ვიზუალური ხელოვანის, ფიონა დევისის გამოფენა – „სისხლი აბრეშუმზე“.
ღონისძიება 2014 წელს ფიონა დევისის ინიციატივით გაიმართა თბილისში. ამ გამოფენით აბრეშუმის მუზეუმმა უმასპინძლა სახელოვნებო პროექტს, სადაც აბრეშუმის, როგორც მასალის აღქმა და გაგება, სცდებოდა მის ტრადიციულ განსაზღვრებას. თავად ფიონა დევისი ტრანსდიციპლინურ კვლევაზე დაფუძნებით ამუშავებს თავის იდეებს და წარმოადგენს მათ კონტექსტურ ვიზუალიზაციას.
სისხლი აბრეშუმზე აერთიანებს რამდენიმე დარგის სპეციალისტის ხედვას (ფიზიკოსი პიტერ დომაჩუკი, მწერალი ლი-ან ჰოლი და თავად ვიზუალური ხელოვანი ფიონა დევისი). ამ ხედვების ურთიერთგადაკვეთაზე, ინსტალაციის საშუალებით, მაყურებელი სისხლისა და აბრეშუმის კავშირებზე ფიქრდება.
გამოფენა გვიჩვენებდა ბიომედიცინის მიღწევას, რომლის მიხედვით აბრეშუმისგან შექმნილი ბიოჩიპით ადამიანის სისხლის კვლევა – ანალიზების აღება ფიზიკური ინტერვენციის გარეშე ხდება შესაძლებელი. ფიონა დევისისთვის ეს მიგნება პერსონალური პერსპექტივიდან გახდა შთამაგონებელი. კერძოდ, აბრეშუმის ბიოჩიპის კვლევა ფიონა დევისის პირად ისტორიას და მამამისის გარდაცვალებას უკავშირდება. ხელოვანი მამამისის ხანგრძლივ, მძიმე დაავადებასთან ბრძოლის პროცესში იყო ჩართული და უშუალოდ ხედავდა, თუ რამდენად რთული პროცესია ინტენსიური ლაბორატორიული ანალიზების აღება ასეთი პაციენტებისათვის. სისხლისა და აბრეშუმის კავშირი აღნიშნულ პროექტში ასევე დაკავშირებულია ბიოპროდუქტებით (სისხლი, ორგანოები) ვაჭრობასთან. ინსტალაციით ხელოვანი აბრეშუმის ქაღალდის ფაქიზ ფაქტურაში „ამოგზაურებდა“ მნახველს, რაც ერთგვარ კომპლექსურ სააზროვნო ბადეს ქმნიდა; ხელით დამუშავებული რუკებისა და ჩანახატების მეშვეობით, ინსტალაცია აბრეშუმის სავაჭრო ისტორიულ-გეოგრაფიულ გზას, ბიოპროდუქტებით ვაჭრობასთან კავშირში გაიაზრებდა და სვამდა ღია კითხვებს ვაჭრობისა და გაყიდვადი პროდუქტის შესახებ.
ღია კითხვების ფორმირებით თანამედროვე ხელოვნების კვლევაზე ორიენტირებული პრაქტიკები ადამიანის შემეცნების სპექტრს აფართოებს. ფიზიკური შეგრძნების და მენტალური კავშირის სინთეზით, ხელოვნებით შესაძლებელია სივრცული პერსპექტივების აღმოჩენა, სადაც მნახველი ნამუშევრის ზემოქმედების უშუალო თანაგანმცდელი და თანამონაწილე ხდება.
მაშინ, როდესაც პოსტმოდერნიზმის აქტიურ ფაზებში გაისმოდა კრიტიკა „ხელოვნების დასასრულის“ / „ხელოვნების სიკვდილის“ შესახებ (არტურ დანტოს / ჰანს ბელტინგის თეორიები), ამგვარი პესიმიზმი ხელოვნებაზე მაინც ისტორიოგრაფიის ხაზოვან ღერძზე აღმოჩნდა კონცენტრირებული. ამ თეორიით თავად ხელოვანის, როგორც სუბიექტივისტური თვითგამოხატვის მქონე ავტორის კრიზისს ვხედავთ.
თუმცა, მაშინ, როდესაც პიროვნული კრიზისი სამყაროს დესტრუქციულ მიმართებას ერწყმის, ხედვის ჰორიზონტი შეიძლება შეიცვლოს. ამ შეცვლილი პერსპექტივიდან ახალი ჰორიზონტი – „განშლადი ველი“ იწყებს ვიბრირებას. ჩემთვის ეს ვიბრირებადი, მარადცვალებადი და გარდაქმნადი მიმართება აღმოჩნდა ინტერესის საგანი, ის „მეტაფაზა“, რომელიც ამჟღავნებს ეკოხედვაზე დაფუძნებულ სახელოვნებო პრაქტიკებს.
ამგვარი ხედვის ერთ-ერთი მიმართულებაა ბიოლოგიური ხელოვნება (ცოცხალი ხელოვნება), რომელიც არ არის დასრულებულ ნამუშევარზე ორიენტირებული მიმდინარეობა ან მანიფესტი. როგორც მკვლევარი ორონ კეტსი განსაზღვრავს, ტრანსჰუმანიზმის იდეებზე დაფუძნებით, ხელოვნების ეს ფორმა ეფემერული, გარდამავალია. შესრულების ინტენსივობა განსაზღვრავს ნამუშევრის მნიშვნელობას. პროცესზე აქცენტით, ის არ რჩება სივრცეში, მაგრამ მეხსიერებაში გარდაიქმნება, როგორც „წმინდა“ გამოცდილება. თანამედროვეობისა და მათ შორის უახლესი ხელოვნების დესაკრალიზებულ მოცემულობაში, სანახაობითი ელემენტი და სიმულაციური შთაბეჭდილება მაყურებლის მიზიდულობას განაპირობებს.
ამის საპირისპიროდ, „ცოცხალი ხელოვნება“ ჰედონისტური აღმაფრენის ნაცვლად, ქმნის დაძაბულობას – დისკომფორტს. ის არ იწყებს თამაშს პოსტმოდერნისტული ესთეტიკითა და ანტიესთეტიკით, არც ფილოსოფიურ კონცეპტუალიზმსა თუ ვიზუალისგან დაცლილ სტრუქტურას გვთავაზობს.
რა იდეასა და მიმართებას შეიძლება გვთავაზობდეს ბიოლოგიის, ცოცხალი ორგანიზმებისა და სახელოვნებო პრაქტიკის სინთეზი? კორეული წარმომავლობის ანიკა იი ნიუ-იორკში მცხოვრები არტისტია, რომელიც სწორედ ამ თანაკვეთაზე ავითარებს მსჯელობას. ხელოვანი ერთ-ერთ ინტერვიუში აღნიშნავს, რომ „იდეები ჰგავს ვირუსებს, რომელთაც შეუძლიათ გადახტომა/გადაადგილება უჯრედის სხვადასხვა კედელში, სინთეზის და მუტაციის შედეგად კი სხვადასხვა სახეობის ხელოვნების ნამუშევრები ფორმირდება.“
თავისთავად ასეთი მიდგომით ხელოვნება შედის იმ ტერიტორიაზე, სადაც ნორმატიული ხედვით მისი ადგილი არ არის. 2015 წელს, ებოლა ვირუსის გავრცელებისას, ანიკა იი ბიოლოგ ტალ დანინოსთან ერთად იკვლევდა ზოგადად ჰიგიენის და ბაქტერიის საკითხებს. მან საკუთარი კვლევა ფემინისტური პოზიციით წარმოადგინა საგამოფენო სივრცეში – Kitchen, გამოფენით „შენ შეგიძლია დამიძახო F” (You can Call Me F).
100-ზე მეტი ქალის სხეულიდან აღებული ბაქტერიული ნიმუშები ხელოვანმა გამოზარდა და წარმოადგინა ადგილ-სპეციფიკურ ნამუშევრად. მონაწილე ქალებს თავად შეეძლოთ გადაეწყვიტათ სხეულის რა ნაწილიდან აიღებდნენ ნიმუშს – ეს შეიძლება ყოფილიყო პირიც და ვაგინაც.
გალერეის სივრცეში საკარანტინო კარვების ინსტალაცია წარმოადგენდა ქალის ფიგურის იდეურ კავშირს ვირუსულ პათოგენთან, რომელიც, გარეგანი ჩარევის მიუხედავად, რეზისტენტული და ადაპტირებადია. სუნი, როგორც შეგრძნების ერთ-ერთი ყველაზე მძაფრი ელემენტი, აქ ფიზიკურად აჟღერებდა ხელოვანის მთავარ კითხვას – „რა სუნი აქვს ფემინიზმს?“ ქალის სხეულისა და ჰიგიენის საკითხების ამგვარ ცოცხალ პროცესად წარმოჩენისას ანიკა იი შეეხო „პატრიარქალურ შიშს“.
სუნის შეგრძნებით და ბაქტერიებზე უშუალო დაკვირვებით, ქალის სხეული შეპირისპირებული აღმოჩნდა ქალურობის მასკულინურ ობიექტივიზაციასთან. მკვლევარი კაროლინ ჯონსი ანიკა იის ამ მიდგომას განსაზღვრავს, როგორც იმის ძიებას, თუ როგორია „გრძნობების (შეგრძნებების) ბიოპოლიტიკა“.
შეგრძნებების ბიოპოლიტიკა გარკვეულწილად გვაფიქრებს აღქმისა და ადამიანური გონის შესაძლებლობებზეც. შიში და ეჭვი, რომელიც ტექნოკრატულ საზოგადოებაში მექანიზებული თუ ხელოვნურად წარმოებული ინტელექტის მიმართ ჩნდება, ბუნებრივი რეაქციონერული მიდგომაა ადამიანის დომინაციური პოზიციიდან. როგორც მკვლევარი და ფილოსოფოსი ქეთი ჩუხროვი განმარტავს, ის, რაც არ არის ადამიანური (inhuman), ისტორიის მიჯნაზე ტრადიციულად აღქმული და გაგებული იყო, როგორც სრულიად უცხო. მაგრამ ეს სრულიად უცხო (alineted otherness), ჩუხროვის განხილვით, გერმანულ იდეალიზმში არ არის განდევნილი და მიუწვდომელი ადამიანური გონისთვის.
პირიქით, არამსგავსი, განსხვავებული ადამიანური გონის შემეცნებაში წამყვან პოზიციას იკავებს კანტთან. ჰეგელთანაც აბსოლუტური გონი მიღწევადია უნივერსალური პრიზმიდან და ის თანაარსებობს ადამიანური გონების განზოგადებულ სიბრტყეში. თანამედროვე დებატები არაადამიანურის (inhuman) ცნების შესახებ არ გულისხმობს ადამიანის უგულებელყოფას თუ განდევნას. თანამედროვეობა, გონის ხელოვნური ელემენტების კვლევით, შეისწავლის ტვინის ქმედების ფენომენს. ნეიროფსიქოლოგიურ კვლევებზე დაყრდნობით ტვინის ფუნქციონირება მოიცავს მექანიკურ ელემენტებს. ამ მსჯელობაში ჩუხროვთან არაადამიანური (inhuman) და ადამიანური არ უპირისპირდება ერთმანეთს, არამედ ეხმიანება ჰეგელისეული ინტელექტის/ შეცნობის წადილის ნომინალურ და აბსტრაქტულ წვდომას.
აბსტრაქტული წვდომისა და განსხვავებული ხედვების ურთიერთგადაკვეთის მაგალითად შეგვიძლია განვიხილოთ ფრანგი ხელოვანის, პიერ იუჟის გამოფენა – UUmwelt. გამოფენის სახელწოდება ითარგმნება, როგორც გარემო და ესტონელი ბიოლოგის, იაკობ ფონ უექსკულის თეორიიდან არის აღებული. იაკობ ფონ უექსკული მე-20 საუკუნის დასაწყისში იკვლევდა და განიხილავდა სხვადასხვა სახეობის განსხვავებულ აღქმით სპეციფიკებს.
დიფუზიური გარემოს შექმნით პიერ იუჟი სამყაროში ადამიანურისა და ხელოვნურის ურთიერთგანმასხვავებელ სტრუქტურებს ჰიბრიდული კავშირებით წარმოადგენს. ეკრანული გამოსახულებებიც, რომლებიც გალერეაში იყო წარმოდგენილი, არაფიქსირებულ, ვიბრირებად ვიზუალებს ქმნიდა.
ეს არ არის მხატვრის ფანტაზია და გამოგონილი სამყარო. გამოსახულებები მიღებულია ადამიანის გონის რეალური დაფიქრების შედეგად. ნამუშევრები იაპონური კინეტიკის ლაბორატორია Kamitani-სთან თანამშრომლობით შეიქმნა.
წინასწარ მიწოდებულ გამოსახულებებზე დაფიქრებით ხდებოდა მონაწილეების ტვინის ტალღების სკანირება. მიღებული გამოსახულებები, განთავსებული საგალერეო სივრცეში, არამკაფიო, დაძაბულ, გადაფარვად აღქმებს აფიქსირებდა. როგორც იუჟი აღნიშნავს, ის თავისი ფიქრის მოდიფიცირებას ახდენს, და ასეთი მოდიფიცირებული რეალობა გარდაიქმნება არა როგორც სიმულაციურად, არამედ ხელშესახებად, ფიზიკურად.
იუჟი სივრცის პირველადი ზემოქმედებით ზღვარს შლის ფიზიკურ და აუგმენტურ (ნახევრად ვირტუალურ) რეალობებს შორის. დროითი საზღვრების პირობითობა კი მნახველის თვალწინ თანადროულობის შეგრძნებას ამძაფრებს. მნახველის მზერა – იუჟის განსაზღვრებით, „საზოგადო მზერა“ – „მენტალურ გამოსახულებებში“ გადადინებად, განმასხვავებელ მიმართებებს ამჟღავნებს, სადაც ურთიერთდაკავშირება ურთიერთდამოკიდებულების პრიზმაში გადასვლაც არის.
აღქმის ამგვარი პლურალური მოდელი, ვფიქრობ, დაპირისპირებაა დღევანდელ სამომხმარებლო ყოფასთან, ე.წ. სპექტაკლის საზოგადოებასთან (გი დე ბორი) – თანამედროვე სოციუმთან, რომელიც სიმულაციურ, ილუზორულ ტყვეობაში აღმოჩნდა.
„სპექტაკლის საზოგადოების“ კრიტიკულ ტექსტში გი დე ბორი აღნიშნავს, რომ „ყველაზე ამქვეყნიური სიცოცხლე სულ უფრო მეტად ბუნდოვანი და სულის შემხუთველი ხდება“ [თარგმანი – ლაშა ხარაზი]. ეს პროცესი ინტენსიურია იმდენად, რამდენადაც აღქმის ფიქციურმა მითოგენებმა გამოიწვია გაუფასურება – სანახაობაზე ორიენტირებული მიდგომა, სადაც ადამიანური გონება სამყაროსთან სრულ გათიშულობაშიც შეიძლება აღმოჩნდეს.
ამგვარი ქმედება თავისთავად დესტრუქციულობის საფუძველია. „საკუთარი ნაწარმისგან განცალკევებული ადამიანი თვითონვე სულ უფრო ძლიერად აწარმოებს საკუთარი სამყაროს ყველა დეტალს და შესაბამისად, საკუთარი სამყაროსგან სულ უფრო და უფრო განცალკევებული ხდება. ახლა, რაც უფრო მეტად არის მისი ცხოვრება მისი ნაწარმი, მით უფრო მეტად განცალკევებულია იგი მისივე ცხოვრებისგან“. [„სპექტაკლის საზოგადოება“, ლაშა ხარაზის თარგმანი]
სამყაროსთან ამგვარად განცალკევებული ადამიანი განწირულია. განწირულობა და სიცოცხლის სიმყიფე მკაფიოდ გამოვლინდა პანდემიის საერთო კრიზისულ ვითარებაში. უცხო სხეულმა – კორონავირუსმა – შეგვახსენა ცვლილებების აუცილებლობა, სადაც სანახაობის საზოგადოება მოაზროვნე საზოგადოებად ფორმირებას საჭიროებს. ეს ალტერნატივაა – მიმღებლობა სამყაროსადმი, მისი ბუნებრივად არსებული მრავალფეროვნების შემეცნება და ამ შემეცნებაში თანაარსებობა.
ცოდნა, რომელსაც „ცოცხალი ხელოვნება“ ავითარებს, უარს ამბობს ადამიანის ცალსახა თვითტკბობით, ნარცისულ პოზიციებზე. ამგვარი უარყოფით ფუკოსეული ხედვა ბიოლოგიური სხეულის პირველად მნიშვნელობასა და ბიოპოლიტიკის წარმოებაზე ახალ განსაზღვრებებს იძენს.
პოლ პრესიადო ესეში – „ვირუსისგან ვსწავლობთ“ აღნიშნავს: „ყველაზე მნიშვნელოვანი, რაც ფუკოსგან ვისწავლეთ, არის ის, რომ ცოცხალი (შესაბამისად, მოკვდავი) სხეული ყველანაირი პოლიტიკის მთავარი ობიექტია. არ არსებობს პოლიტიკა, რომელიც სხეულის პოლიტიკა არ არის“.
ამ მოსაზრების განვრცობით, მეტაფაზა ამჟღავნებს საზოგადოების სოციალური სხეულის ფორმირებას – ერთგვარ პარადიგმას, სადაც ცოცხალი და მოკვდავი ადამიანური სხეული, უცხო სხეული და განსხვავებული ცოცხალი ორგანიზმები ერთიანი ეკოსისტემის განუყოფელი ნაწილებია.
* სტატია მომზადებულია კუნტსჰალე თბილისის პროექტის ფარგლებში, ღია საზოგადოების ფონდის მხარდაჭერით.